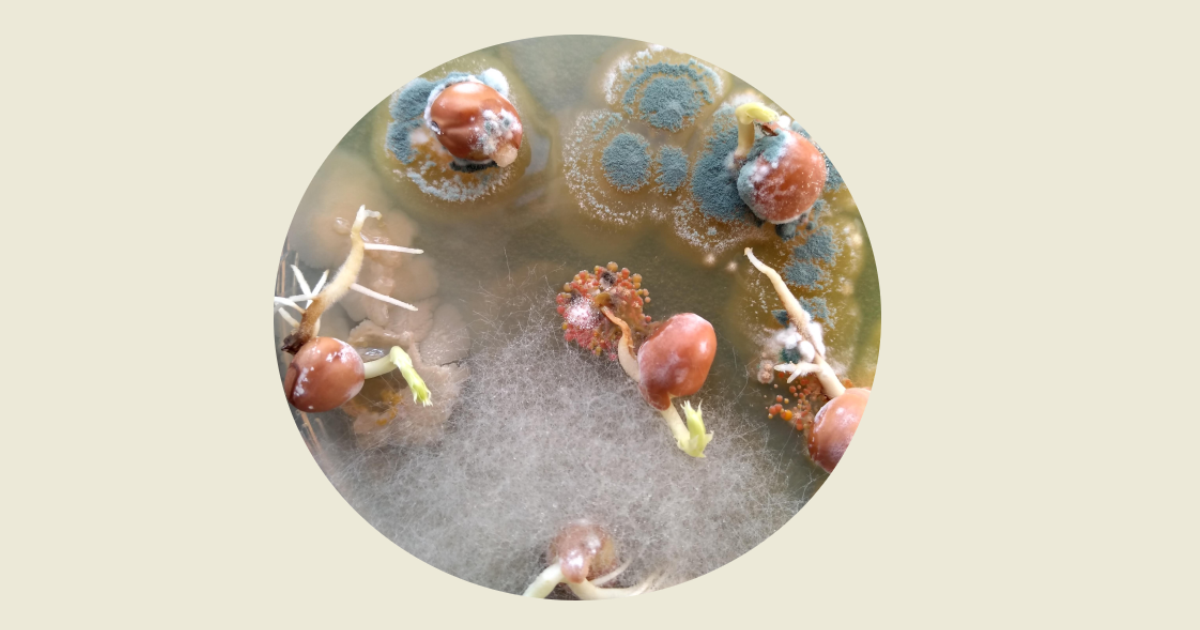
Graphical abstract

- 3.3Impact Factor
- 6.8CiteScore
- 14 daysTime to First Decision
Plant Pathogenic Fungi
This special issue belongs to the section “Fungal Pathogens“.
Special Issue Information
Dear Colleagues,
Plant pathogenic fungi encompass a large and diverse assemblage of eukaryotes with significant impacts on human health and natural ecosystems. Many fungal diseases are caused by multiple pathogens with lack of discriminatory morphological characteristics. In addition, traditionally defined pathogens have often been found to be species complexes containing a large number of cryptic species. Knowledge on their hidden diversity appears to be critical to understand the evolution of pathogenicity and to identify their biosafety and biosecurity threats. Biotrophic fungi are often obligate pathogens growing within living plant cells, and typically have narrow host ranges. Necrotrophs often use toxins, cell-wall-degrading enzymes, and ROS to promote disease and macerate plant tissues. Some pathogens exhibit both types of nutrition, switching from biotrophic to necrotrophic growth. Both genomics and proteomics hold promise to identify the pathogenicity and virulence factors of fungi and their mechanisms of resistance in order to minimize their adverse effects. This Special Issue welcomes high-quality contributions (original research papers and reviews) that shed light on any aspect of plant pathogenic fungi, with the new methods enabling their efficient detection and identification, etiology, epidemiology, pathogenesis, and pathogenomics. Experimental studies, case reports, and review papers are all welcome.
Prof. Dr. Tomasz Kulik
Guest Editor
Manuscript Submission Information
Manuscripts should be submitted online at www.mdpi.com by registering and logging in to this website. Once you are registered, click here to go to the submission form. Manuscripts can be submitted until the deadline. All submissions that pass pre-check are peer-reviewed. Accepted papers will be published continuously in the journal (as soon as accepted) and will be listed together on the special issue website. Research articles, review articles as well as short communications are invited. For planned papers, a title and short abstract (about 250 words) can be sent to the Editorial Office for assessment.
Submitted manuscripts should not have been published previously, nor be under consideration for publication elsewhere (except conference proceedings papers). All manuscripts are thoroughly refereed through a single-blind peer-review process. A guide for authors and other relevant information for submission of manuscripts is available on the Instructions for Authors page. Pathogens is an international peer-reviewed open access monthly journal published by MDPI.
Please visit the Instructions for Authors page before submitting a manuscript. The Article Processing Charge (APC) for publication in this open access journal is 2200 CHF (Swiss Francs). Submitted papers should be well formatted and use good English. Authors may use MDPI's English editing service prior to publication or during author revisions.
Keywords
- fungal disease
- detection and identification of plant pathogenic fungi
- pathogenomics
- plant fungal infection
- plant pathology
Benefits of Publishing in a Special Issue
- Ease of navigation: Grouping papers by topic helps scholars navigate broad scope journals more efficiently.
- Greater discoverability: Special Issues support the reach and impact of scientific research. Articles in Special Issues are more discoverable and cited more frequently.
- Expansion of research network: Special Issues facilitate connections among authors, fostering scientific collaborations.
- External promotion: Articles in Special Issues are often promoted through the journal's social media, increasing their visibility.
- e-Book format: Special Issues with more than 10 articles can be published as dedicated e-books, ensuring wide and rapid dissemination.

